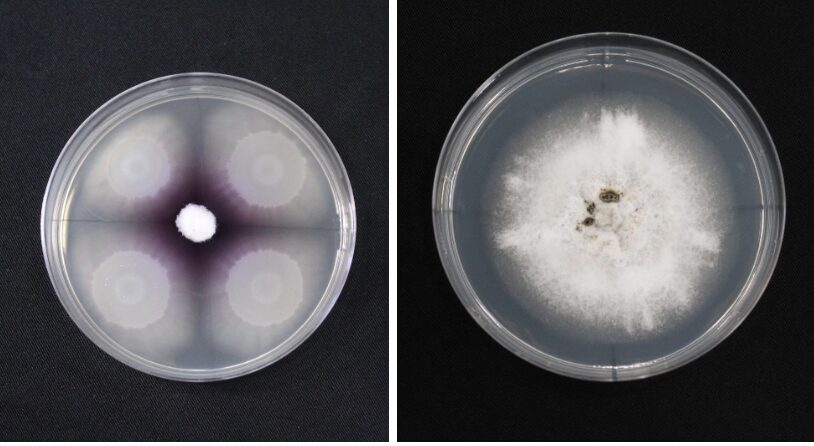
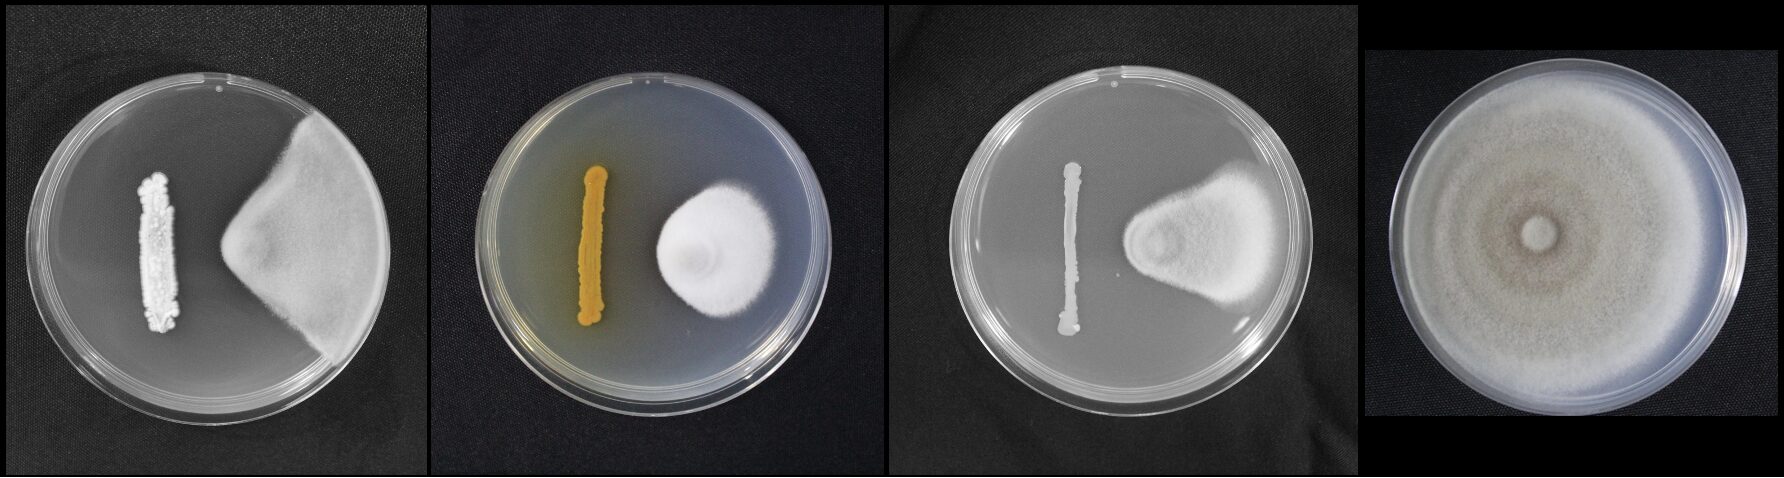

Gustavo Mamao is head of international business development at IdeeLab, the foremost Brazilian contract development and manufacturing organization (CDMO) in ag biologicals.
The views expressed in this article are the author’s own and do not necessarily represent those of AgFunderNews.
The past few years have brought growing excitement around ag biologicals, products made from naturally derived inputs—such as microbes, plant extracts, or biochemicals—used to enhance crop protection, soil health, and plant growth.
Market reports forecast consistent double-digit growth over the next few years, with the global market expected to nearly double, from $13.6 billion in 2024 to $24.6 billion by 2030, according to DunhamTrimmer. Some projections even suggest that biologicals could surpass their chemical counterparts within 10 to 20 years, capturing a significant share of the current $80 billion crop protection and $200 billion fertilizer markets.
Two decades ago, when I co-founded a biological control company in Brazil, we were stepping into uncharted territory. There was no established market for biocontrol products, just a promising idea and a belief that agriculture could be more sustainable. Regulators in Brazil didn’t know what to make of us; we were treated almost like a chemical pesticide company. At the time, ag biologicals wasn’t even a recognized category. What we had was a vision, supported by the deep technical expertise of my business partner and the scientific credibility of the university where he worked. It wasn’t glamorous! We were building from scratch, learning as we went, and doing our best to move the field forward.
Slowly, we were able to break through the farm gates, evangelize early adopters, and prove the concept on multiple fronts, including scaling up the production of a beneficial microbe. Eight years after its first funding round, the company was acquired by a major market player in the special ag input products sector. The deal returned 5x the capital invested by a pioneering seed fund, which was brave enough to back the company’s investment thesis at that time.
Having taken on a new role in this field over the last year, and through reading and watching presentations, I now wonder: Why hasn’t a clear investment thesis for ag biologicals fully emerged? What would it take to define one that truly reflects today’s opportunity?
Breaking the agtech categorization puzzle
Much has been said about the recent decline in venture capital flowing into agrifoodtech. According to a recent AgFunderNews article, the first half of 2025 saw the lowest level of agrifoodtech funding since 2015, reflecting a broader trend across the VC landscape.
However, to truly understand what this means, we first need to unpack what agrifoodtech encompasses. Others have raised this point in popular LinkedIn posts, and even AgFunderNews has reflected on the pros and cons of having popularized a term that tends to blur very distinct businesses.
To build a coherent investment thesis for ag biologicals, we may need to break agrifoodtech not just into agtech and foodtech, but go further, recognizing that even within agtech, vastly different types of ventures are grouped.
For example, product discovery in biologicals has more in common with drug or chemical molecule development than it does with, say, ag robotics. Yet, because these inputs are naturally derived, they don’t fully align within those costly and time-consuming frameworks found in chemical ag—a nuance increasingly recognized by regulators worldwide.
Making these distinctions also helps avoid common investment biases across the broader field, especially since different segments are often at very different stages of the Gartner Hype Cycle. While some areas of food and agriculture are trending down, Ag Biologicals are trending up, moving steadily along the “slope of enlightenment.”

Ag biologicals basics/fundamentals
Any solid analysis of ag biologicals should start with a basic and specific product and innovation development phasing. The following steps are critical:
Discovery and validation: After an initial understanding of the potential of naturally derived agro inputs, backed by scientific publications and the technical knowledge of researchers or entrepreneurs, initial data on a potential product application is produced, and the product undergoes the initial phases of testing, including field trials and fine-tuning.
Regulatory approval: For most biological applications and global markets, companies must fulfill specific regulatory requirements based on product category. Note that most of these still come from previous chemical crop protection and fertilizer regulatory frameworks. A lot is happening here, both in the biocontrol and biostimulant arenas. Companies and investors may need to consider the current regulatory status as well as some potential new laws that have been under discussion and may be applied when a product registration is ready to be filed.
Go-to-market (in two phases):
1. Soft launch. According to the most recent Stratus Ag Research, confidence with farmers is built over two to three years of positive trial results. Therefore, you cannot scale up sales of a product just based on a fad (as some food/CPG products rely on). It takes time to educate, apply, and learn how to improve the product in the field, so a minimum time is necessary to build critical mass.
2. Full launch. After a few years of product demonstrations and established commercial proofs of concept, the distribution channel penetration becomes a critical milestone, allowing the product to be offered for large-scale consumption by farmers.
Another critical distinction needs to be made within ag biologicals itself. The advancement of synthetic biology, a field that combines biology, engineering, and computer science to design and build new biological technologies, unlocks the potential for the development of a new generation of biological products. Proteins and peptides, GMOs, and RNAi-derived products are among them. As they are part of the scientific knowledge frontier, some higher regulatory barriers exist, which can result in longer timelines to capture value, as well as higher levels of capital infusion.
The following table represents a summary of traditional development platforms of ag biological products, some of the most common business activities, and estimated timelines:
Aligning company goals and investor expectations
There is inherent uncertainty in most early-stage ventures in this space, though not all companies—especially in the biostimulant landscape—face the same level of product development risk. For simplicity, however, let’s assume that equity investment is needed to support these companies.
Among many venture capital thesis parameters, there are two critical ones that investors will always take into consideration: the potential multiple return of an investment, and the timeline between the investment and disinvestment, or exit.
Some early-stage investment benchmarks encourage investors to maintain a large portfolio to increase the odds of finding the few outliers that deliver returns well above the average. In ag biologicals, however, billion-dollar exits have not yet occurred, which makes such outliers less common. As a result, the likelihood of achieving higher-than-average returns (e.g., over 10x) may be lower.
On the other end of the spectrum, the agro-biological market is becoming mature and large enough to avoid significant investment losses. An investor should assume higher chances of intermediary returns, closer to the average ranges, or a multiple of 5x.
The following table can illustrate what a return on investment of ag biological could look like compared to the benchmark of average early-stage investment expectation:

Source: Moonfire, author analysis
In terms of timeline, assuming a VC industry benchmark average of seven years, ag biotech investment can offer exit opportunities around this timeframe. There are two valuation inflection points considered good exit opportunities for investors, with both cases being attractive to an acquirer to incorporate the new product as part of their portfolio:
- Once a key product of a company has the regulatory approval in one of the largest world biological markets (US, Brazil, Europe, Canada, etc.)
- Once a company has decided to pursue the go-to-market soft launch and build a strong reputation in one area and/or type of crop
Another, more sophisticated scenario—especially when analyzing the return of an early-stage investor—occurs when a new company decides to build a larger portfolio of products and compete for distribution channels. The largest valuation will arise in this scenario, associated with the need for larger amounts of capital infusion to scale the company’s operations. In this case, the seven-year timeline for an exit may be reinterpreted in relation to the later rounds of capital infusion (Series A-D). Still, it is not expected for a company with less than 10 years of its foundation to reach an exit.
While the regulatory process is not flexible enough to incorporate continuous product improvements, it is expected that the product discovery and validation phase can keep pace with specific product improvements or new releases. The go-to-market (soft launch) can benefit from more product trials even before complete product approval. The following picture summarizes the overall idea, assuming the case of a single product or tech-platform of ag biological products:

Reality-check for ag biological companies value creation
There are areas of constraints for ag biological value creation, and they should be factored into a well-tailored investment thesis, avoiding misalignment with entrepreneurs based on false expectations:
Product adoption is slow to take off. If investors are accustomed to CPG products that can be boosted by hype or by testimonials from celebrity influencers, their mindset may not be well-suited to the time it takes to earn a farmer’s trust.
On the other hand, a slow but well-executed product education effort can generate lasting results—reaching critical mass after a few years and leveraging farmer satisfaction to drive organic growth.
Distribution challenges and market fragmentation. Distribution is one of the primary pain points for ag investors, and several industry failures can be traced to ventures that underestimated how deeply agriculture is built on relationships. You can’t simply buy and consolidate distribution channels as in other sectors, because most of the time, you’re not acquiring the critical last-mile relationships—those that truly influence purchasing decisions and enable bundled solutions.
Each crop requires a deep well of specialized knowledge and has its own key opinion leaders (KOLs). Focus is essential: it’s better to develop one market well—by region or crop—than to stretch resources across many scattered efforts.
Regulatory hurdles. As noted earlier, regulatory timelines vary by region and product category. A misstep in the process—or external events like agency backlogs or staff shortages—can significantly affect financial outcomes.
The best course is to secure experienced advisors, invest in those relationships, and understand that the regulatory journey may take up to five years. Be ready to respond quickly and thoroughly to questions from regulatory bodies at any stage of the process.
To the investor community: Unlocking the full potential of ag biological opportunities may not require chasing only the largest exits.
Instead, aligning expectations with the unique return profile and risk dynamics of this sector can open the door to more sustainable, long-term outcomes. By backing a promising subcategory winner and exploring diverse growth pathways—such as out-licensing or strategic distribution partnerships—investors can tap into a range of value-creation opportunities, including compelling exit options over time.
Similarly, while the traditional venture capital mindset often emphasizes speed, ag biologicals may benefit from a more calibrated timeline. Yet, choosing the right path and pacing it well can yield lasting rewards.
The post Guest article: A deep dive into the investment thesis for ag biologicals appeared first on AgFunderNews.
